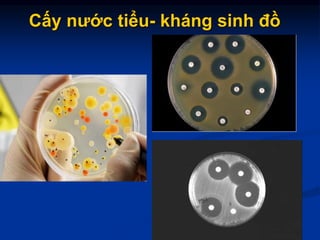
Cấy nước tiểu- kháng sinh đồ

Tài liệu cung cấp thông tin chi tiết về các triệu chứng, định nghĩa, phân loại và chẩn đoán nhiễm trùng tiểu, bao gồm viêm bàng quang, viêm thận bể thận cấp và mạn tính, cũng như các yếu tố nguy cơ và phương pháp xét nghiệm. Nó phân tích các loại vi khuẩn gây nhiễm trùng, cơ chế đề kháng, cùng với quy trình cấy nước tiểu và các xét nghiệm bổ sung. Tài liệu cũng nhấn mạnh sự khác biệt trong triệu chứng và biến chứng giữa nhiễm trùng tiểu không biến chứng và có biến chứng.